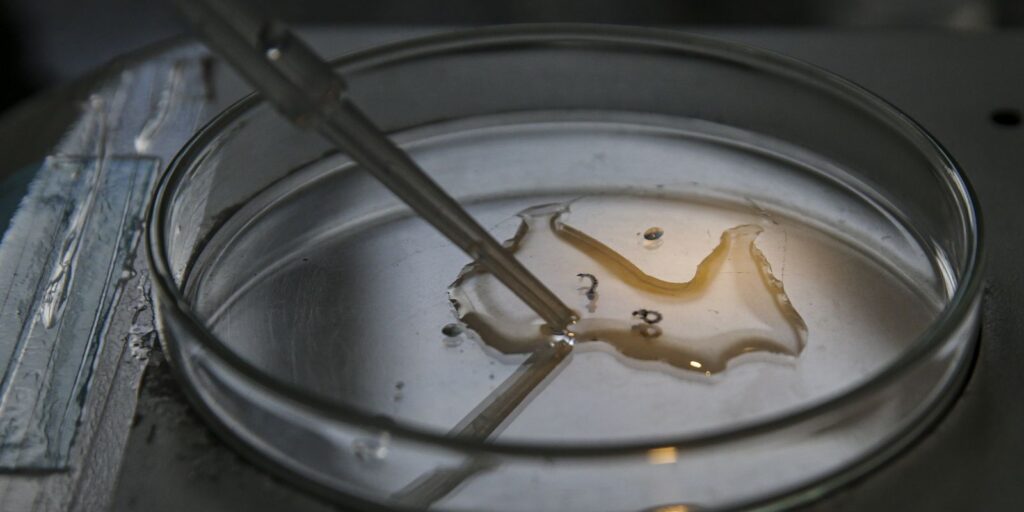

O Ministério da Saúde realiza neste sábado (2), em todo o país, o Dia D de Mobilização contra a Dengue. O objetivo do evento, denominado Brasil unido contra a dengue, é fazer uma ação integrada de mobilização nacional em todas os estados, convocando a sociedade civil, influenciadores digitais, mídia e atores locais para conscientizar a população sobre características da dengue e procedimentos de prevenção.![]()
![]()
Com o tema Dez minutos contra a dengue, a mobilização nacional pretende reforçar as ações de prevenção e eliminação dos focos do mosquito. Segundo o Ministério, a ação terá a participação maciça de agentes de saúde, ministros, governadores, prefeitos e secretários para serem porta-vozes do combate ao mosquito Aedes aegypti.
Nesta semana, a ministra da Saúde, Nísia Trindade, se reuniu com os secretários estaduais de Saúde do país para mobilizar os estados em torno da iniciativa e reforçar as ações de prevenção e eliminação dos focos do mosquito. Durante o encontro, a ministra enfatizou a necessidade da união dos entes da federação para o enfrentamento do surto da doença.
“Este é um momento de atenção não só das autoridades sanitárias, do Ministério da Saúde, mas também de toda a sociedade”, alertou.
Desde o início do ano, o Brasil registrou 1.038.475 casos prováveis de dengue e 258 mortes confirmadas pela doença. Outros 651 óbitos estão em investigação. O coeficiente de incidência da dengue no país neste momento é de 511,4 casos para cada grupo de 100 mil habitantes, segundo o Painel de Monitoramento das Arboviroses.
Campanha
O governo federal lançou recentemente a campanha Dez minutos contra a dengue. O conteúdo sugere ao cidadão que separe dez minutos por semana para o combate à dengue, já que cerca de 75% dos criadouros estão nos domicílios.
A ideia é que esse tempo é suficiente para garantir que caixas d´água estejam bem fechadas, jogar areia nos vasos de planta, garantir que os sacos de lixo estejam bem amarrados, conferir calhas, evitar pneus em locais descobertos, não acumular sucatas e entulhos e esvaziar garrafas PET, potes e vasos.
Crédito arquivo Nacional EBC
Leia Mais em: O Maringá

